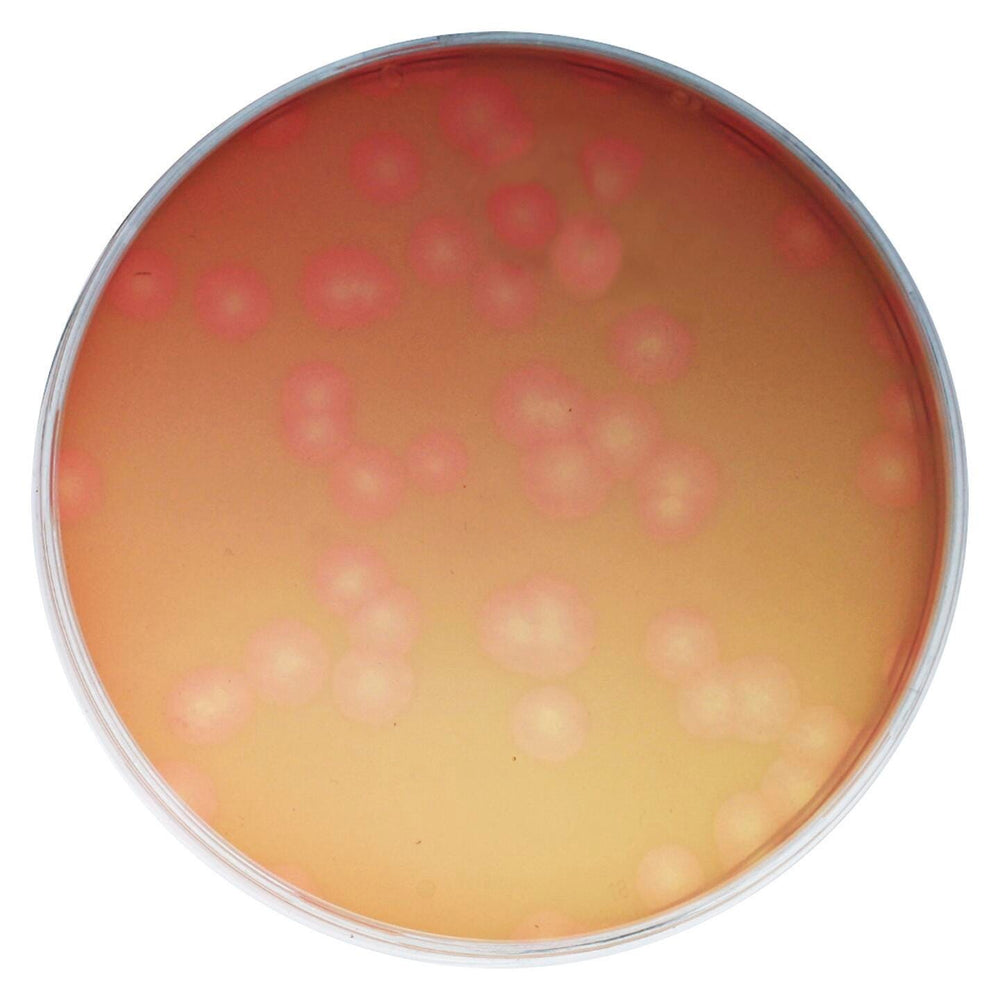

Exclusive Institutional Rates for Schools
Guaranteed On-Time Supply for Every Term
Dedicated Support for School Procurement
Term-Start Essentials
Delivery all
over the UAE

Code: 113O15496
Delivery: 60-90 Days
Brand: School Specialty
Type of Packages: Pi
Edvotek Exploring the Bacteriophage Life Cycle Kit
Thanks for subscribing!
This email has been registered!